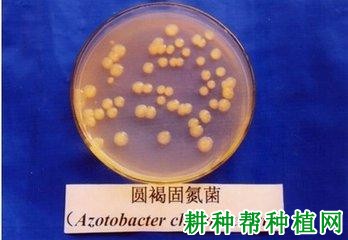

固氮菌
肥料(azotobacter fertilizer),是指含有益的固氮菌, 能在土壤和多种作物根际中固定空.气中的氮气,供给作物氮素营养,又能分泌激素刺激作物生长的活体制品。是以能够自由生活的固氮微生物或与一些禾本科植物进行联合共生固氮的微生物作为菌种生产出来的。
肥料?" alt="什么是固氮菌肥料?"> 肥料?" alt="什么是固氮菌肥料?">
肥料?" alt="什么是固氮菌肥料?"> 按菌种及特性分为自生固氮菌、共生固氮菌和根际联合固氮菌。
1、自生固氮菌是指一类不依赖于其他生物共生而能独立在土壤里固定空气中的氮,供给作物氮素营养,又能分泌激素刺激作物生长的微生物,如自生固氮菌属的圆褐固氮菌。
2、共生固氮菌是指必须与其他生物共生才能进行固氮的微生物,如与豆科植物共生结瘤的各种根瘤菌。
3、根际联合固氮菌是既依赖根际环境生长,又在根际中固定空气中的氮气,对作物的生长发育产生积极作用的微生物,联合固氮菌微生物生活在植物的根内、根表,可以利用一些禾本科植物,尤其是C4植物根分泌的一些糖类繁殖、固氮,也能进行自生固氮,如固氮螺菌、雀稗固氮菌等。
用于固氮菌
肥料生产的菌株主要采用圆褐固氮菌属、氮单胞菌属的菌种。根际联合固氮菌可采用下列菌种:固氮螺菌、阴沟肠杆菌、粪产碱菌和肺炎克氏杆菌。
肥料?" alt="什么是固氮菌肥料?"> 肥料?" alt="什么是固氮菌肥料?">
肥料?" alt="什么是固氮菌肥料?"> 固氮菌
肥料其最大特点是不与高等植物共生,独立生存于土壤中,能固定空气中的氮素,并能将其转化成植物可利用的氮素化合物。固氮菌对磷、钾需要量较大,既能利用空气中的分子态氮,又能利用土壤中的化合态氮。对土壤酸性反应敏感,适宜的PH值为7.4~7.6,酸度增加时,固氮能力降低。对土壤湿度要求较高, 当土壤湿度为田间最大持水量的25%~40%时才开始生育,60% 时生育最旺盛。固氮菌属中温性细菌,最适宜的生长温度为25~30℃。固氮菌所固定的氮素量较少,大大低于根瘤菌的固氮量,但固氮菌在生长繁殖过程中,能产生多种植物激素类物质。
肥料?" alt="什么是固氮菌肥料?"> 肥料?" alt="什么是固氮菌肥料?">
肥料?" alt="什么是固氮菌肥料?"> 国内的产品剂型有固体固氮菌
肥料、液体固氮菌
肥料和冻干固氮菌
肥料。质量标准为农业行业标准,代号为NY411—2000。
菌种在含一种有机碳源的无氮培养基中能固定分子氮, 并具有一定的固氮效能。菌体一般为短杆状(固氮螺菌属菌体呈螺旋状),革兰氏染色阴性。
①自生固氮菌。用固氮菌属、氮单胞菌属的菌种,也可用茎瘤根瘤菌和固氮芽孢杆菌菌株。
②根际联合固氮菌。可用固氮螺旋菌;阴沟肠杆菌经鉴定为非致病菌的菌株;粪产碱菌经鉴定为非致病菌的菌株;肺炎克氏杆菌经鉴定为非致病菌的菌株。
使用以上规定之外的菌种生产固氛菌
肥料时,菌种必须经过鉴定。生产固氣微生物
肥料所使用的菌种,必要时还要进行菌种染色鉴别和菌种固氮效能测定。
该标准对包装、标识、运输和贮存规定如下。
①液体
肥料小包装用塑料瓶或玻璃瓶,大包装用塑料桶。固体
肥料用不透明聚乙烯塑料包装。冻干菌剂用玻璃指形管真空干燥。外包装采用纸箱,箱外用尼龙打包带加固。
②每箱(袋)产品中附有产品合格证和使用说明书,在使用说明中标明使用方法、用量及注意事项。
③在包装箱(袋)上印有产品名称、商标、标准编号、
肥料登记号、生产单位、厂址、生产日期、批号和净重,并印有防晒、防潮、防冻等标记,若有必要还要加印易碎、防倒置等标记。内包装上有产品名称、商标、标准编号、
肥料登记号、有效菌含量、生产日期、有效期、产品性能、使用说明书及生产单位、厂址等。
④适用于常用运输工具,运输过程中有遮盖物,防止雨淋、日晒及35℃以上高温。气温低于0℃时采取保温措施,防止菌肥冻冰。运输过程中轻装轻卸,避免包装破损。
⑤产品贮存在阴凉、干燥、通风的库房内,最适温度为10~25℃,不得露天堆放,以防雨淋和日晒,避免冻冰及长时间35℃以上高温。
肥料?" alt="什么是固氮菌肥料?"> 肥料?" alt="什么是固氮菌肥料?">
肥料?" alt="什么是固氮菌肥料?"> 固氮菌适用于各种作物,特别是禾本科作物和蔬菜中的叶菜类,可作种肥、
基肥和追肥。如与有机肥、
磷肥、
钾肥及微量元素
肥料配合施用,能促进固氮菌的活性,固体菌剂每亩用量250~500克,液体菌剂每亩100毫克,冻干菌剂每亩500~1000亿活菌。合理施用固氮菌肥,对作物有一定的增产效果,增产幅度在5%左右。土壤施用固氮菌肥后,一般每年每亩可以固定1~3千克氮素。
1、拌种:作种肥施用,在菌肥中加适量的水,倒入种子混拌,捞出阴干即可播种。随拌随播,随即覆土,避免阳光照射。
2、蘸苗根:对蔬菜、甘薯等移栽作物,可采用蘸苗根的方法。
3、
基肥:可与有机肥配合施用,沟施或穴施,施后立即覆土。薯类作物施用固氮菌剂时先将马铃薯块茎或甘薯幼苗用水喷湿,再均匀撒上菌肥与肥土的混合物,在其未完全干燥时就栽培。
4、追肥:把菌肥用水调成糊状,施于作物根部,施后覆土, 或与湿肥土混合均匀,堆放三五天,加稀粪水拌和,开沟浇在作物根部后盖土。
肥料?" alt="什么是固氮菌肥料?"> 肥料?" alt="什么是固氮菌肥料?">
肥料?" alt="什么是固氮菌肥料?"> ①固氮菌属中温性细菌,在25~30℃条件下生长最好,.温度低于10℃或高于40℃时生长受到抑制,因此,固氮菌肥要保存于阴凉处,并要保持一定的湿度,严防暴晒。
②固氮菌对土壤湿度要求较高,当土壤湿度为田间最大持水量的25%~40%时,固氮菌才开始繁殖,至60%时繁殖最旺盛, 因此,施用固氨菌肥时要注意土壤水分条件。
③固氮菌对土壤酸性反应敏感,适宜的pH值为7.4~7.6, 酸性土壤在施用固氮菌肥前应结合施用石灰调节土壤酸度,过酸、过碱的
肥料或有杀菌作用的
农药,都不宜与固氮菌肥混施,以免发生强烈的抑制。
④固氮菌只有在碳水化合物丰富而又缺少化合态氮的环境中, 才能充分发挥固氮作用。土壤中碳氮比低于(40~70):1时,固氮作用迅速停止。土壤中适宜的碳氮比是固氮菌发展成优势菌种、固定氮素最重要的条件。因此,固氮菌最好施在富含有机质的土壤上,或与有机
肥料配合施用。
⑤应避免与速效氮同时施用。土壤中施用大量
氮肥后,应隔10天左右再施固氮菌肥,否则会降低固氮菌的固氮能力。但固氮菌剂与磷、钾及微量元素
肥料配合施用,则能促进固氮菌的活性,特别是在贫瘠的土壤上。
⑥固氮菌
肥料多适用于禾本科作物和蔬菜中的叶菜类作物, 有专用性的,也有通用性的,选购时一定要仔细阅读使用说明书。
⑦在固氮菌
肥料不足的地区,可自制菌肥。方法是选用肥沃土壤(菜园土或塘泥等)100千克、柴草灰1~2千克、过磷酸钙0.5千克、玉米粉2千克或细糠3千克拌和在一起,再加入厂制的固氮菌剂0.5千克作接种剂,加水使土堆湿润而不粘手,在25~30℃中培养繁殖,每天翻动一次并补加些温水,堆制3~5天,即为简法制造的固氮菌
肥料。自制菌肥用量每亩为10~20千克。
